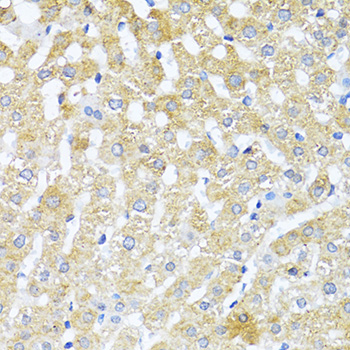
Immunohistochemistry - TGFB2 Polyclonal Antibody

-
Product Name
TGFB2 Polyclonal Antibody
- Documents
-
Description
Polyclonal antibody to TGFB2
-
Tested applications
WB, IHC, IF
-
Species reactivity
Human, Mouse, Rat
-
Alternative names
TGFB2 antibody; G-TSF antibody; LDS4 antibody; TGF-beta2 antibody; transforming growth factor beta-2 antibody
-
Isotype
Rabbit IgG
-
Preparation
Antigen: Recombinant fusion protein containing a sequence corresponding to amino acids 20-160 of human TGFB2 (NP_001129071.1).
-
Clonality
Polyclonal
-
Formulation
PBS with 0.02% sodium azide, 50% glycerol, pH7.3.
-
Storage instructions
Store at -20℃. Avoid freeze / thaw cycles.
-
Applications
WB 1:500 - 1:2000
IHC 1:50 - 1:200
IF 1:50 - 1:200 -
Validations
Immunohistochemistry - TGFB2 Polyclonal Antibody
Immunohistochemistry of paraffin-embedded rat liver using TGFB2 antibody at dilution of 1:100 (40x lens).

Immunohistochemistry - TGFB2 Polyclonal Antibody
Immunohistochemistry of paraffin-embedded human liver using TGFB2 antibody at dilution of 1:100 (40x lens).

Immunohistochemistry - TGFB2 Polyclonal Antibody
Immunohistochemistry of paraffin-embedded human liver cancer using TGFB2 antibody at dilution of 1:100 (40x lens).

Immunohistochemistry - TGFB2 Polyclonal Antibody
Immunohistochemistry of paraffin-embedded mouse heart using TGFB2 antibody at dilution of 1:100 (40x lens).
-
Background
Transforming growth factor beta-2 proprotein: Precursor of the Latency-associated peptide (LAP) and Transforming growth factor beta-2 (TGF-beta-2) chains, which constitute the regulatory and active subunit of TGF-beta-2, respectively.; Latency-associated peptide: Required to maintain the Transforming growth factor beta-2 (TGF-beta-2) chain in a latent state during storage in extracellular matrix (By similarity). Associates non-covalently with TGF-beta-2 and regulates its activation via interaction with 'milieu molecules', such as LTBP1 and LRRC32/GARP, that control activation of TGF-beta-2 (By similarity).; Transforming growth factor beta-2: Multifunctional protein that regulates various processes such as angiogenesis and heart development. Activation into mature form follows different steps: following cleavage of the proprotein in the Golgi apparatus, Latency-associated peptide (LAP) and Transforming growth factor beta-2 (TGF-beta-2) chains remain non-covalently linked rendering TGF-beta-2 inactive during storage in extracellular matrix (By similarity). At the same time, LAP chain interacts with 'milieu molecules', such as LTBP1 and LRRC32/GARP, that control activation of TGF-beta-2 and maintain it in a latent state during storage in extracellular milieus (By similarity). Once activated following release of LAP, TGF-beta-2 acts by binding to TGF-beta receptors (TGFBR1 and TGFBR2), which transduce signal (By similarity).
Related Products / Services
Please note: All products are "FOR RESEARCH USE ONLY AND ARE NOT INTENDED FOR DIAGNOSTIC OR THERAPEUTIC USE"
